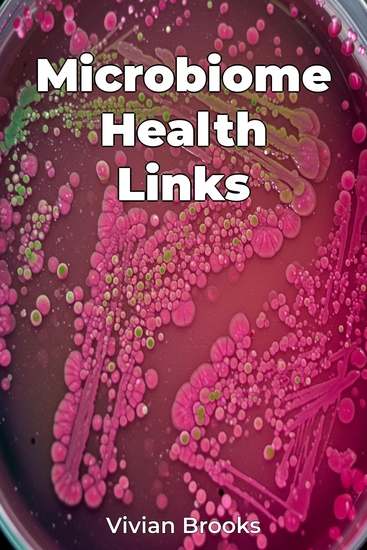

Microbiome Health Links
Vivian Brooks
Übersetzer A AI
Verlag: Publifye
Beschreibung
Microbiome Health Links explores the fascinating world of the human microbiome, the trillions of bacteria in our gut, and its profound impact on overall Health & Fitness. It reveals how imbalances in the gut microbiome can affect not only digestion but also immunity and even mental health, emphasizing the crucial link between Gut Health and wellness.Emerging research suggests that the gut-brain axis, the communication pathway between gut bacteria and the brain, influences mood and cognition. The book uniquely translates complex scientific information into practical advice for a general audience. It begins by establishing the fundamentals of microbiome science, then progresses to examine the roles of specific bacteria, the influence of diet and lifestyle, and the connection between gut dysbiosis and various diseases.Novel therapeutic interventions, including Probiotics and Prebiotics, are also explored. This approach empowers readers to make informed decisions about their diet and lifestyle, offering evidence-based strategies to improve their own Gut Microbiome. By understanding the principles of gut health, readers can personalize their approach to wellness, optimizing their microbiome for improved health outcomes.














